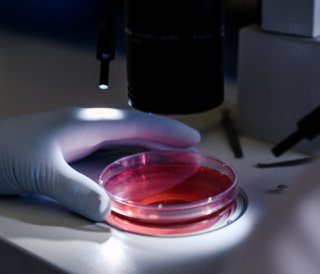

Швидкість отримання результатів має критичне значення для репродуктивної медицини. Більшість досліджень виконуються в стислі терміни, що дозволяє не втрачати цикл лікування. Оперативна передача результатів аналізів лікарю дає змогу швидко коригувати терапію. Такий підхід актуальний при контролі гормональної терапії та передопераційних аналізах. Саме лабораторна точність формує основу успішного лікування безпліддя.Екс перти медичного центру «Мати та дитина» зазначають:
«У репродуктології лабораторна діагностика фактично визначає стратегію лікування — від природного планування до складних програм ЕКЗ».
Гормональні аналізи при безплідді
Гормональний баланс є ключовим фактором функціонування репродуктивної системи. Будь-які зміни рівня гормонів можуть порушувати овуляцію, сперматогенез або імплантацію ембріона. Саме тому гормональні аналізи входять до стандарту обстеження пари. Вони дозволяють оцінити роботу гіпофіза, яєчників, щитоподібної залози та наднирників. Комплексна оцінка гормонального профілю формує основу діагностики.
Обстеження необхідне як жінці, так і чоловіку, адже чоловічий фактор безпліддя зустрічається майже в половині випадків. Аналізи дозволяють визначити ендокринну природу проблем із фертильністю, адже часто саме приховані гормональні відхилення стають причиною невдалих спроб зачаття. Вчасна діагностика дозволяє провести корекцію ще до початку лікування. Це підвищує ефективність програм ДРТ.
Контроль рівня гормонів важливий і під час лікування. Повторні дослідження застосовуються для оцінки відповіді організму на терапію. Лікар отримує можливість коригувати медикаментозне навантаження. У такий спосіб зменшується ризик гіперстимуляції або гормонального дисбалансу.
Пацієнткам часто рекомендують здати кров на гормони у визначені дні циклу. Це дозволяє отримати клінічно точні показники, тоді як порушення термінів здачі може спотворити результати. Саме тому всі дослідження виконуються за рекомендацією репродуктолога, а індивідуальний підхід залишається ключовим принципом.
Основні гормони для жінок
Оцінка жіночої фертильності починається з визначення рівнів ФСГ та ЛГ. Ці гормони регулюють дозрівання фолікулів і процес овуляції. Підвищені або знижені показники можуть вказувати на дефіцит оваріального резерву. Дані використовуються для планування стимуляції. Вони безпосередньо впливають на вибір протоколу.
Антимюллерів гормон (АМГ) є головним маркером репродуктивного потенціалу. Він відображає запас яйцеклітин незалежно від фази циклу. Саме рівень АМГ допомагає прогнозувати відповідь яєчників на стимуляцію. Це критично при підготовці до ЕКЗ.
Естрадіол та прогестерон дають змогу оцінити функціональну активність яєчників. Вони визначають готовність ендометрію до імплантації. Недостатній рівень прогестерону може ускладнювати настання вагітності. Контроль цих гормонів важливий після перенесення ембріона. Аналіз використовується також для моніторингу лікування.
Пролактин і ТТГ відображають стан ендокринної регуляції. Порушення роботи щитоподібної залози часто асоціюється з безпліддям і невиношуванням вагітності. Навіть субклінічні відхилення можуть впливати на цикл. Корекція гормонального фону підвищує шанси на вагітність. Саме тому ці показники входять у стандартні аналізи при безплідді.
Гормональні аналізи для чоловіків
Оцінка чоловічої фертильності починається з визначення рівня тестостерону. Він відповідає за сперматогенез і статеву функцію. Зниження показника може впливати на якість сперми. Аналіз допомагає виявити ендокринні причини безпліддя. Це базове дослідження для андрологічної діагностики.
ФСГ і ЛГ дозволяють оцінити роботу гіпофіза. Вони відображають регуляцію утворення сперматозоїдів. Порушення рівнів можуть свідчити про первинне або вторинне безпліддя. Дані важливі для визначення подальшої тактики лікування. Часто вони доповнюють результати спермограми.
Пролактин також впливає на чоловічу репродуктивну функцію. Його підвищення може пригнічувати синтез андрогенів. Це негативно позначається на фертильності. Корекція рівня гормону покращує результати лікування. Тому дослідження входить в аналізи для чоловіків при безплідді.
Комплексна оцінка гормонального статусу дозволяє визначити чоловічий фактор безпліддя. Дані потім використовуються для вибору медикаментозної терапії. Вони допомагають прогнозувати ефективність ДРТ. Водночас гормональна діагностика часто поєднується з генетичними дослідженнями, що забезпечує комплексний підхід до вирішення проблем із зачаттям.
Аналізи перед програмою ЕКЗ
Перед початком циклу ЕКЗ проводиться повний перелік обстежень. Аналізи перед програмою ЕКЗ спрямовані на оцінку безпеки лікування. Вони дозволяють виключити протипоказання до стимуляції та вагітності. До базового комплексу входить інфекційний скринінг:
- аналіз на ВІЛ;
- аналіз на гепатити B і C;
- сифіліс;
- урогенітальні інфекції.
Такі дослідження захищають здоров’я матері та майбутньої дитини. Вони необхідні для роботи ембріологічної лабораторії. Важливою частиною обстеження є коагулограма. Вона оцінює систему згортання крові перед стимуляцією. Додатково виконуються біохімічний аналіз крові та загальний аналіз крові. Ці показники відображають стан організму. Вони допомагають знизити ризики ускладнень.
Строки дії результатів мають клінічне значення. Більшість досліджень актуальні 3–6 місяців, тоді як частина інфекційних тестів — лише 1 місяць. Лікар контролює актуальність перед початком циклу, тож аналізи для ЕКЗ часто планують заздалегідь.
Аналізи при плануванні вагітності
Комплексні аналізи при плануванні вагітності дозволяють оцінити готовність організму до зачаття. Вони спрямовані на профілактику ускладнень вагітності. Дослідження рекомендовані навіть при відсутності діагностованого безпліддя. Це сучасний стандарт відповідального батьківства, адже рання діагностика підвищує шанси на здорову вагітність.
TORCH-панель дозволяє визначити імунітет до небезпечних інфекцій. До цього комплексу входять дослідження на токсоплазмоз, краснуху, цитомегаловірус і герпес. Ці інфекції можуть впливати на розвиток плода, а їх своєчасне виявлення дозволяє провести профілактику.
Обов’язково визначаються група крові та резус-фактор. Це важливо для запобігання резус-конфлікту. Додатково перевіряється функція щитоподібної залози. Рівень ТТГ впливає на перебіг вагітності. Корекція показників проводиться до зачаття.
Оцінка загального стану здоров’я передбачає лабораторні базові дослідження. Вони дозволяють виключити анемію або метаболічні порушення. Результати враховуються при плануванні вагітності. Це допомагає уникнути ризиків у майбутньому.
Лабораторні аналізи для чоловіків при безплідді
Причиною труднощів із зачаттям часто стає стан здоров'я партнера. Тому аналізи для чоловіків при безплідді є обов’язковими. Основним дослідженням залишається спермограма. Вона оцінює концентрацію, рухливість і морфологію сперматозоїдів, в’язкість та час розрідження сперми та інші показники, що дозволяють визначити репродуктивний потенціал чоловіка.
Інфекційний скринінг допомагає виключити запальні процеси, адже хронічні інфекції можуть погіршувати якість сперми. Такі дослідження виконуються одночасно з гормональною діагностикою, щоб забезпечити комплексну оцінку чоловічого здоров’я. Лікування в разі виявлення відхилень від нормативних показників призначається індивідуально.
Гормональні аналізи включають дослідження рівнів тестостерону, ФСГ, ЛГ та пролактину. Вони відображають ендокринну регуляцію сперматогенезу. Відхилення можуть бути оборотними при правильній терапії. Крім того, контроль гормонів дозволяє оцінювати ефективність лікування. За показаннями призначаються додаткові дослідження:
- MAR-тест;
- генетичні аналізи;
- фрагментація ДНК сперматозоїдів;
- ультразвукова діагностика.
- Такі обстеження застосовуються при складних формах безпліддя.
Як підготуватися до здачі лабораторних аналізів
Правильна підготовка забезпечує точність результатів. Наприклад, більшість досліджень крові виконують натще, тож рекомендується утриматися від їжі за 8–12 годин до процедури, а допускається лише вода (але іноді не можна також пити). Це стандартна вимога лабораторної діагностики.
| Тип аналізу | Основні правила підготовки | Чого треба уникати |
|---|
| Аналіз крові | Натще (останнє приймання їжі — за 8–12 годин до аналізу) | Їжа, алкоголь |
| Гормональні аналізи | У визначені дні циклу | Самостійний вибір дати |
| Спермограма | Статеве утримання — 3–5 днів | Перегрів, алкоголь |
| Коагулограма | Без фізичних навантажень | Інтенсивний спорт |
| TORCH-комплекс | Без гострих захворювань | Приймання імуномодуляторів |
Вживання медикаментів може впливати на показники. Пацієнт повинен повідомити лікаря про всі препарати, що приймає на постійній основі. Іноді необхідна тимчасова відмова від ліків. Самостійно припиняти терапію не можна. Узгодження проводиться з лікарем.
Гормональні дослідження залежать від фази циклу. Наприклад, ФСГ та ЛГ здають на початку циклу. Прогестерон визначають після овуляції. Недотримання термінів знижує інформативність аналізу. Саме тому графік визначає репродуктолог.
Перед здачею аналізів варто уникати фізичних перевантажень і стресу, рекомендується повноцінний сон. Всі рекомендації надаються індивідуально для максимальної точності діагностики.
Переваги здачі лабораторних аналізів у медичному центрі
Репродуктивна спеціалізація лабораторії має вирішальне значення. У медцентрах «Мати та дитина» дослідження адаптовані саме під потреби ДРТ. Це дозволяє уникнути непотрібних аналізів, а отже, і витрат. Пацієнт отримує цільову діагностику.
Координація з лікарем-репродуктологом пришвидшує лікування. Результати аналізів одразу потрапляють до медичної системи. Це виключає втрату часу. Лікар може швидко скоригувати лікування. Особливо це важливо під час стимуляції.
Сучасна лабораторна база забезпечує високу точність досліджень. Використовуються автоматизовані аналізатори. Контроль якості відповідає європейським стандартам. Це сприяє точності результатів. Надійність лабораторії є критичною для ЕКЗ.
Лікарі медичного центру «Мати та дитина» підкреслюють: «Синхронна робота лабораторії та репродуктолога дозволяє скоротити шлях пацієнта до вагітності».

Вiдгуки